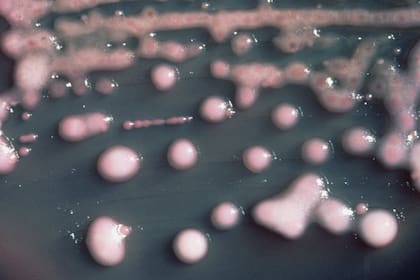
Una de las bacterias halladas es la Klebsiella pneumoniae

“Prácticamente, no hay tratamiento”: las dos bacterias halladas en el fentanilo suministrado a nueve pacientes fallecidos
Se infectaron 18 personas en un hospital de La Plata tras recibir el analgésico; Ralstonia pickettii y Klebsiella pneumoniae resisten a los antibióticos habituales
6 minutos de lectura'
Nueve pacientes murieron como consecuencia de infecciones invasivas graves asociadas con el uso de fentanilo contaminado, elaborado en la planta de Laboratorios Ramallo, en la localidad bonaerense homónima, sin buenas prácticas de manufactura y para un laboratorio con sucesivas prohibiciones de comercialización.
Información de la investigación en curso indica que se habría detectado en las ampollas de fentanilo contaminación con las bacterias Ralstonia pickettii y Klebsiella pneumoniae productora de metalobetalactamasa (MBL). Ambas estaban presentes en las muestras tomadas a pacientes del Hospital Italiano de La Plata y en dos casos que se investigan en Rosario, Santa Fe. En el Instituto Malbrán se están cotejando todas las muestras.
Los 18 pacientes que activaron las alertas estaban internados en la unidad de terapia intensiva del mencionado hospital privado de la capital provincial. Empezaron con fiebre por la presencia de las bacterias en sangre (bacteriemia) e hipotensión. La mitad de ellos fallecieron. La infección invasiva generó un shock séptico que terminó siendo fatal.
Todos habían recibido por vía endovenosa dosis de ampollas del lote 31202 del opiáceo comercializado por la firma HLB Pharma, con vencimiento el 29 de septiembre de 2026. La fecha de elaboración es 12 de diciembre del año pasado.
El jueves pasado, la Anmat alertó al sistema de salud sobre la prohibición de uso del lote de fentanilo de HLB (presentación por 100 ampollas de 5ml en solución inyectable, certificado N° 53.100) por una denuncia de contaminación cruzada. La Región Sanitaria XI de la provincia de Buenos Aires a la que corresponde La Plata había notificado un brote de infecciones invasivas por Klebsiella pneumoniae productora de MBL y Ralstonia pickettii en pacientes tratados con ese producto.
El laboratorio del Hospital Italiano detectó la presencia de ambas bacterias en muestras tomadas a los pacientes de terapia intensiva con neumonía y las envió al laboratorio nacional de referencia en el Malbrán, donde confirmaron los resultados.
A partir de la alerta en ese centro privado, se notificaron otros dos casos en el sistema público y privado de Rosario, Santa Fe, que se están investigando. Así, el total de afectados ascendería a 20.
Angela Famiglietti, codirectora de la Carrera de Especialización en Bioquímica Clínica área Bacteriología Clínica de la Facultad de Farmacia y Bioquímica de la Universidad de Buenos Aires (UBA), ahondó sobre las características de las bacterias identificadas y explicó que la aparición de una bacteriemia por esos patógenos no es el mejor escenario.

“Klebsiella pneumoniae productora de MBL es una bacteria intrahospitalaria causante de diferentes infecciones, como neumonía, infección del tracto urinario, bacteriemia o sepsis, y por su resistencia a antibacterianos es de difícil tratamiento. Hay que estudiar cómo llegó a contaminar el inyectable -amplió en diálogo con LA NACION-. Ralstonia pickettii es otra bacteria que puede causar, con menor frecuencia, infecciones nosocomiales, como bacteriemia o septicemia por soluciones contaminadas e, inusualmente, infecciones invasivas y graves, como meningitis, artritis séptica, entre otras. Es un patógeno más importante de lo que creíamos. Su importancia clínica, como sucede con Klebsiella pneumoniae productora de MBL, es que tiene resistencia natural a varios antibióticos de uso clínico".
Famiglietti señaló que “existen muy pocas opciones terapéuticas” para Klebsiella pneumoniae productora de MBL “por su extrema resistencia” a las drogas disponibles. “Prácticamente, no hay tratamiento. Se utiliza una combinación de fármacos que es muy costosa”, repasó Famiglietti, profesora consulta de la UBA y exjefa del Departamento de Bioquímica Clínica del Hospital de Clínicas, dependiente de esa universidad. “La Organización Mundial de la Salud la considera de alta prioridad para la salud pública”, agregó.
Tal como había anticipado ayer el Ministerio de Salud, la Anmat formalizó la denuncia penal contra HLB Pharma.
El organismo regulatorio ya dispuso la inhibición de ese laboratorio, que comercializaba el inyectable, y de Laboratorios Ramallo, que elaboraba en su planta productos para HLB que no estaban autorizados. Ahora, tras la muerte de nueve personas, la penalidad publicada hoy en el Boletín Oficial prohíbe “el uso, la distribución y la comercialización” en todo el país de “todos los productos registrados a nombre de HLB Pharma”, con sede en la localidad bonaerense de San Isidro. El lugar, ayer, estaba cerrado.
“En lo que va del año, la Anmat dispuso múltiples sanciones contra el laboratorio HLB Pharma -señalaron-. En febrero de este año, se dispuso la suspensión de actividades de Laboratorios Ramallo, vinculado a HLB Pharma, por deficiencias graves en sus procesos de elaboración”.

En febrero, la autoridad regulatoria había ordenado al laboratorio retirar del mercado ampollas de propofol inyectable (lote 60000) que estaba comercializando sin autorización. El producto, según consta en la denuncia original, no tenía etiqueta de trazabilidad y estaba registrado como especialidad medicinal a nombre de Surar Pharma, una firma inhibida, clausurada y sancionada múltiples veces. Una investigación de LA NACION dio a conocer en 2015 las irregularidades de esa planta. Lo mismo ocurrió con ampollas de dopamina inyectable.
La semana pasada, la Anmat prohibió la comercialización de otros dos productos, también en ampollas, del HLB Pharma: diclofenac sódico (lote 80020) y morfina al 1% (lote 31050). Fue tras una denuncia por contaminación cruzada. Cuando esto ocurre durante la producción, está asociado con malas prácticas de manufactura y se considera un “desvío de calidad crítico” porque implica un riesgo cierto para la salud pública. El Departamento de Vigilancia post Comercialización y Acciones Reguladoras de la Anmat es responsable de supervisar que el laboratorio responsable retire del mercado las unidades de los lotes defectuosos.
Sobre las reiteradas denuncias desde hace más de dos años, hay “soluciones parenterales de gran volumen con contaminaciones microbiológicas y problemas con los envases/sachet”, por ejemplo. En 2023, según constató la Anmat, HLB elaboró en Laboratorios Ramallo 393 lotes de esos productos con un sistema de envasado sin autorización.
El nombre de HLB Pharma estuvo asociado hace cuatro años con el negocio de la compra de vacunas para Covid-19 al Fondo Ruso de Inversión Directa durante el gobierno de Alberto Fernández. En enero de 2021, un mes después de la llegada a Ezeiza de los primeros lotes de Sputnik V, desde el laboratorio confirmaron a LA NACION que habían participado en uno de tres viajes a Rusia de la comitiva argentina de Carla Vizzotti y Cecilia Nicolini para acordar la comercialización de las dosis en el país. Aclararon, también, que el preacuerdo que tenían con representantes del fondo ruso finalmente no se firmó. “El Gobierno decidió corrernos del negocio”, se quejaron, entonces, en diálogo con este medio.
1Simple, pero contundente: la iniciativa para que la sociedad homenajee a los veteranos de Malvinas con un gesto cotidiano
2Pronóstico del tiempo: cuándo vuelve el calor extremo a AMBA, según el último parte del SMN
- 3
Tren Mitre: vuelven a postergar la llegada del servicio a Retiro
- 4
Tren Mitre hasta Retiro: cómo funciona hoy, lunes 9 de marzo





